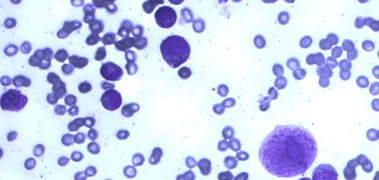
Thumbnail Caption

B19
B19, an erythrovirus, is the causative agent of Nil F. Filatov's Fifth Disease (erythema infectiosum). Discovered in 1974 by Yvonne Cossart, this was the first parvovirus identified.
The receptor for B19 is erthrocyte P antigen (glycosphingolipid tetrahexosecramide also known as globoside). Some people genetically do not have this antigen and are thus not susceptible to B19 infection. While this is the B19 receptor on erythrocytes, there is probably another unknown receptor in respiratory epithelial cells, which would explain respiratory transmission.
B19 causes a characteristic rash across both the face and body of children. Because of this, the symptoms caused by the virus is sometimes referred to as "Slapped Cheek Syndrome" (this can be seen on the child at the top of the page). The syndrome starts with fever and malaise and typically clears in less than one month.
The virus is respiratorally transmitted, and thus is very common among children. In adults, the virus can lead to complication such as arthritis.
The most serious complication of B19 occurs when the virus crosses the placenta and infects a fetus. The virus causes a condition known as hydrops fetalis, in which the fetus swells with fluids. Before the 20th week of pregnancy, there is a 10% chance of spontaneous abortion or stillbirth. Afterward, the risk is minimal. (1,6)


